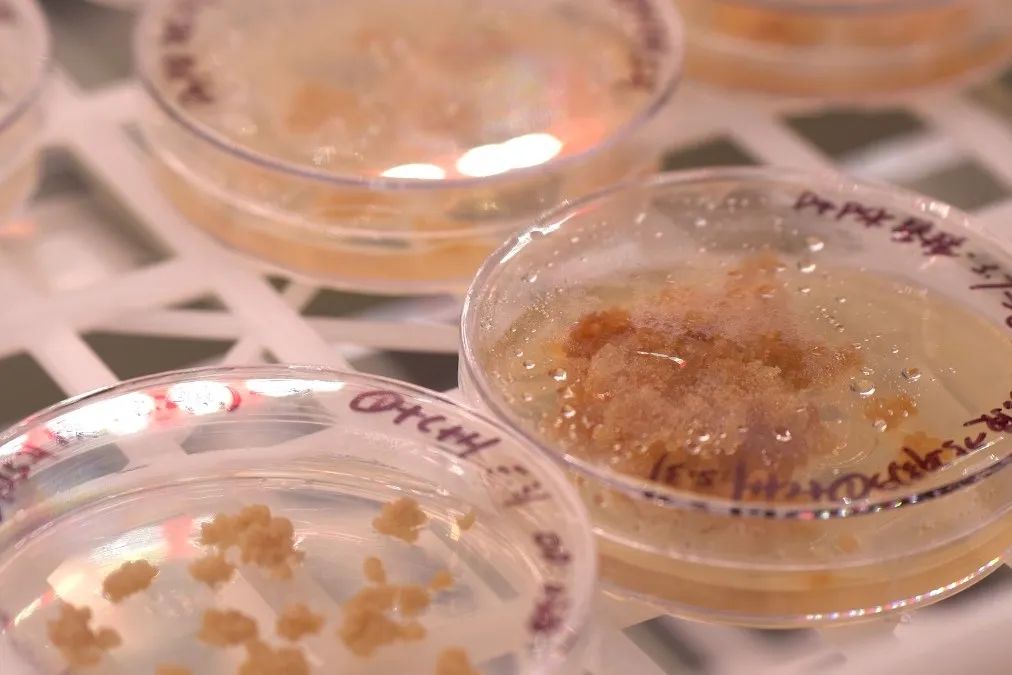
呈贡发布

在呈贡斗南,花卉产业正绽放出别样的科技魅力,成为浪漫与科技交融的典范。作为中国花卉产业的重要发源地之一,斗南不仅有着丰富的花卉资源和深厚的文化底蕴,更在科技的助力下,不断书写着花卉研发的辉煌篇章。




斗南与云南省农业科学院携手,建成了“云南种子种业联合实验室—花卉种业实验室”。这个实验室汇聚了高水平、多层次的花卉种业科研团队,致力于鲜切花、特色盆花种业关键技术研发,紧跟国际先进育种技术,积极引进和推广花卉新品种。截至2024年底,实验室已收集保存月季、百合、洋桔梗等多种花卉资源上千种,开展资源收集、保存、评价及种质资源创新工作,筛选出适应云南低纬高原气候种植的月季品种30余个,申请专利3项,形成花卉绿色生产主推技术3个,并在种植展示区进行了绿色高效种植展示。



通过快速育种方法,实验室选育出8个新品种,重点攻克了切花月季、洋桔梗、百合的无性繁育技术,建立了高标准无性系种苗繁育方法,累计繁育月季新型种苗超过150万苗,推广种植300多亩。这些新品种和繁育技术的突破,不仅丰富了花卉品种,提高了花卉品质,还为花卉产业的可持续发展提供了有力支撑。



在第二届昆明斗南国际花卉展览会上,科技与花卉的融合得到了充分展现。众多企业携千余个花卉品种参展,展示了花卉育种研发创新、新优品种培植、规模化生产示范等领域的最新成果。在新优品种推荐会上,多家育种企业发布了大量新品,如昆明杨月季园艺有限公司推荐的大叶绣球品种群,坂田种苗(苏州)有限公司带来的洋桔梗新品等。这些新品不仅在颜色、形态上独具特色,更体现了科技在花卉育种中的应用。




科技不仅在花卉育种中发挥作用,还贯穿于花卉产业的各个环节。从花卉土壤水肥及病虫害检测,到新品种鉴定、原种保存扩繁、基因编辑等,科技手段的应用提高了花卉生产的效率和质量。同时,物流供应链的优化,如“航空+高铁+冷链”立体运输模式,以及智能化调度系统、自动分流等物联网技术,确保了鲜花的“鲜活”。
斗南花卉产业在科技的助力下,正从传统的花卉种植向现代化、智能化的花卉全产业链升级。这一升级不仅提升了花卉产业的竞争力,也为消费者带来了更多高品质、多样化的花卉产品,让浪漫的花卉产业在科技的赋能下焕发出新的生机与活力。


编审 | 李学刚
终审 | 马玲丽